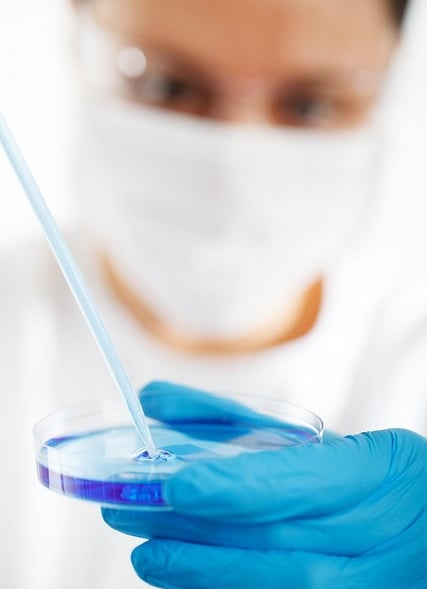
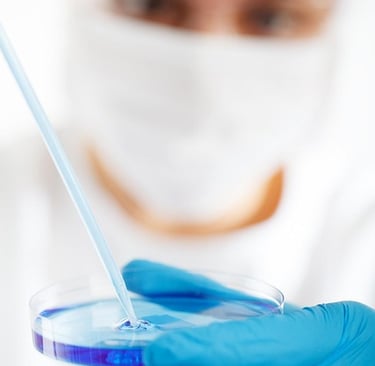

Gallery

Explore our range of pharmaceutical products and services.
Our Services
Comprehensive solutions for healthcare professionals and patients.
Quality Products
Every Adzva product is crafted with care, backed by research and tested for safety to ensure trust and effectiveness.
Therapy And Product Range
Anti-oxidant, Anti-allergy, Anti-acne, Skin brightening, Skin hydrating, Skin Protection
Trusted Care
Quality pharmaceuticals for a healthier tomorrow.
Adzva Pharmaceuticals has transformed my skincare routine with its reliable products and excellent support.
Neha Rawat
Mumbai
The quality and effectiveness of Adzva's products have greatly improved my texture.
Rahul
Jaipur








